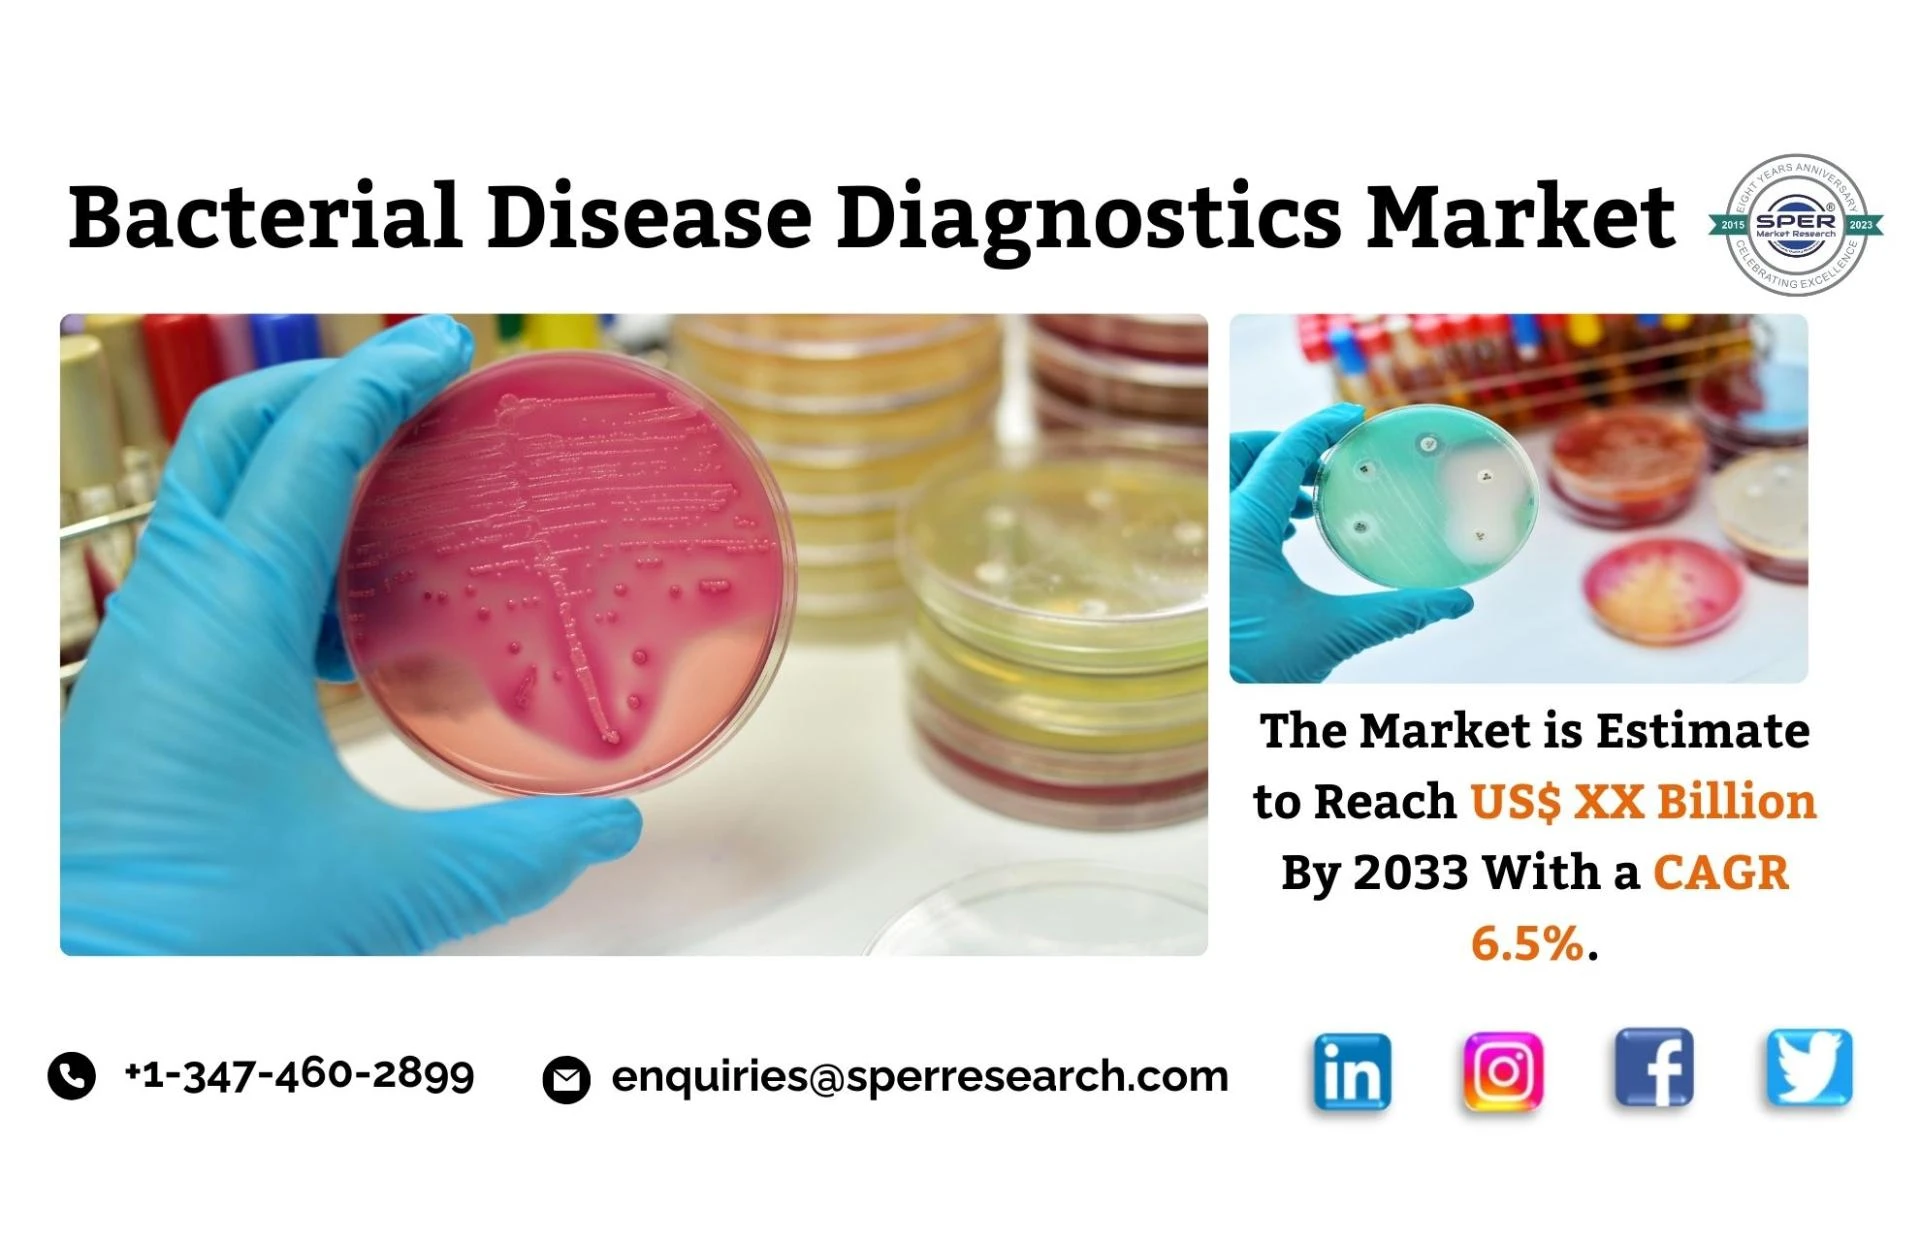

A conveyance system transports water from the catchment to a storage tank, whereas a catchment gathers precipitation in a traditional rainwater collection syste…

The South Korea cloud computing market faces challenges including data privacy concerns and regulatory complexities, requiring compliance with stringent data pr…

They are used in laboratories, hospitals, and specialty clinics to make medical decisions, monitor patients, and provide tailored treatment.

Certain materials are more in demand as a result of these qualities, particularly when creating furniture like office chairs, couches, and bean bags.

Hair care products like shampoos, conditioners, and styling aids promote hair health and manageability.

Medical equipment, such as X-ray machines and blood glucose monitors, is essential to the healthcare sector because of its involvement in diagnosis, treatment, …

They are handheld tools used for food preparation tasks such as stirring, mixing, flipping, cutting, and serving.

Synthetic leather is versatile and used in various industries including fashion, automotive, and furniture.

The government is also focusing on the infrastructure of the CNG and LPG, which is boosting the growth of the market.

In the UK, drivers are legally obligated to carry third-party insurance in order to legally drive a vehicle on public roads.

These costs might prove to be prohibitive for many farmers, particularly those that operate on a small scale or in rural regions.

The food service industry is highly competitive and encompasses anything from fine dining restaurants to street vendors.

The expansion on the world urbanization has additionally added to the expansion in the food consumption.

The pharmaceutical and biotechnology sectors require stringent cold chain management to maintain the efficacy and safety of medications and vaccines.

Warehouse robots offer numerous advantages, including enhanced efficiency, productivity, and precision.

The furniture pieces are precisely designed to combine mechanical improvements with exquisite aesthetics, maximising space.

Tofu, which is made from soybeans, is created by pressing the curds that form into solid white blocks after soy milk has been coagulated.

Business jets let executives and high-net-worth individuals (HNWIs) get to a lot of places fast and easily compared to standard airline travel.

Contemporary facilities management surpasses rudimentary upkeep, encompassing amenities that augment the workplace milieu and workforce satisfaction.

Pharmacy retail stores play an essential part in giving these customized prescriptions, driving the market growth.

Pharmacy retail stores play an essential part in giving these customized prescriptions, driving the market growth.

The market is growing because of factors like rising international tourism, rising disposable incomes, and fast urbanization.

The market is growing because of factors like rising international tourism, rising disposable incomes, and fast urbanization.

The rush for warehouse and logistics is due to the developing interest for web- based business pushing up the rentals for capacity units in China.

The advent of SaaS platforms, enhanced virtual accessibility, and sophisticated security that permit remote management of labor and material components all cont…

Public transportation networks are being expanded to include electrified freight vehicles in order to promote zero-emission public transportation.

Third-party logistics (3PL) services enable companies to focus on their core capabilities by outsourcing operational logistics, from delivery to warehousing.

Fabricators use precise blueprints and structural plans to assure precision and conformity with engineering standards.

The refineries are enormous industrial complexes with a wide variety of facilities and subunits. Every refinery has a different layout and mix of refining proce…

The market dynamics are further influenced by government programmes that support sustainable transportation solutions and fuel technology improvements.

The market dynamics are further influenced by government programmes that support sustainable transportation solutions and fuel technology improvements.

The increased precision, efficiency, and safety offered by these state-of-the-art solutions attract both patients and healthcare professionals.

Hardware for controlling water flow and temperature, such as showerheads, faucets, and handles, is included in bathroom fixtures.

The market for automotive coolants is anticipated to be driven by the expanding demand for ethylene glycol in the automotive sector.

People's payment and account management practices are evolving due to the growing use of online payment systems, especially BNPL services.

Vietnam Telecom Market recorded a growing demand in recent days due to a large increase in the number of populations shifting more towards the adoption of smart…

These items are essential to lifestyle and personal grooming as they arouse feelings, memories, and a sense of identity in addition to being aesthetically pleas…

Carbon black is used as filler in almost all rubber compounds to strengthen and improve their physical properties.

The number of patients requiring diagnostic treatments and testing is increasing as the general public's exposure to and incidence of these conditions grows.

Chemical mixes meant for industrial and sanitary cleaning purposes are known as industrial cleaning chemicals.

These powertrains consists of a CNG fuel tank, a fuel delivery system and an internal combustion engine which has been modified to run on CNG.
The growing demand of portable analytical instruments is an emerging trend in the bacterial disease diagnostics market.

Electric hairbrushes are especially popular among women for straightening, curling, and waving their hair.

An electric vehicle's battery pack's size and efficiency have a significant impact on its performance and range.

The need for testosterone deficit treatment increases along with the number of men who experience testosterone deficiency.

They are essential for preserving peak performance in a variety of driving scenarios, from everyday commuting to high-stress situations like racing.

There are several uses for fuel cells, including in stationary and mobile electronics.

The market is greatly stimulated by government investments in infrastructure projects, such as those involving public transportation, bridges, and roads.

The market is greatly stimulated by government investments in infrastructure projects, such as those involving public transportation, bridges, and roads.

These supplements are intended to improve certain body processes, promote general health, and remedy nutritional shortages.
